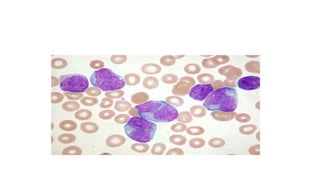

1. The document describes the rules and questions for the AIIMS MEDICINE QUIZ finals with 6 clinical rounds.
2. The rounds involve teams answering direct clinical case questions and having the option to "pounce" on other teams' questions for additional points.
3. Sample questions cover topics like pulmonary actinomycosis, milk-alkali syndrome, necrotizing migratory erythema, beri-beri, hepatic encephalopathy, NMO, and various cardiac conditions.